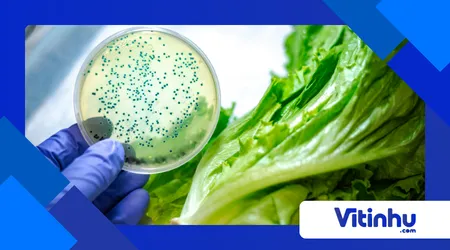
Química da contaminação cruzada

A química da contaminação cruzada: como ela ocorre e como prevenir

Você já passou pela experiência de cortar um morango suculento e, ao morder, sentir um fundinho estranho de alho?
Ou talvez tenha preparado um frango grelhado caprichado, mas acabou com um mal-estar chato horas depois, sem entender o que deu errado, já que a carne parecia bem cozida?
Essas situações, que parecem pequenos mistérios da cozinha, têm uma explicação científica fascinante. Estamos falando da química da contaminação cruzada.
Embora o termo pareça coisa de laboratório, ele acontece todo segundo na nossa bancada. É uma jornada invisível de moléculas e micro-organismos que viajam de um lugar para o outro sem avisar.
Vamos entender como essa “carona” funciona e como manter sua comida segura e saborosa?
O que é essa tal contaminação?
Para a química e a biologia, nada está parado. As superfícies da nossa cozinha — a tábua, a faca, o pano de prato e as nossas mãos — são como rodoviárias movimentadas.
A contaminação cruzada ocorre quando agentes químicos (como o aroma forte de um tempero) ou biológicos (como bactérias) são transferidos de um alimento para outro que não passará pelo fogo.
Imagine que você está manipulando um pedaço de carne crua. Ali existem proteínas e, naturalmente, algumas bactérias que morreriam assim que a carne chegasse a uma temperatura alta na panela.
O problema é quando essas bactérias “pegam carona” na faca e viajam até o alface que você vai comer cru. Como a salada não vai ao fogo, o perigo continua lá.
A química dos cheiros “fofoqueiros”
Sabe por que o gosto da cebola passa para a fruta? Isso acontece por causa de compostos voláteis. A cebola é rica em substâncias que contêm enxofre.
Quando cortamos o vegetal, as células se rompem e liberam essas moléculas, que “amam” gordura.
Se a sua tábua de plástico tiver pequenos cortes com restos invisíveis de gordura, ou se a faca não for lavada com detergente (que quebra essa gordura), essas moléculas de cheiro grudam e pulam para o próximo alimento. É a química da afinidade agindo bem diante dos nossos olhos.
++ Queijos caseiros: a química entre enzimas e proteínas do leite
Como as bactérias viajam?
Bactérias não têm pernas, mas são excelentes surfistas. Elas utilizam a umidade para se locomover. Quando você encosta um alimento úmido em uma superfície, cria-se uma ponte líquida microscópica por onde micro-organismos podem transitar livremente.

Por que isso acontece?
| Elemento | Papel na Contaminação |
| Umidade | Serve como estrada para as moléculas e seres vivos. |
| Porosidade | Esconderijo para resíduos que o olho humano não enxerga. |
| Tempo | Quanto mais tempo de contato, maior a transferência. |
| Temperatura | O calor do ambiente ajuda as bactérias a se multiplicarem rápido. |
Experimento: O Invisível Revelado
Quer ver a contaminação acontecer de forma segura? Esse é um ótimo teste para entender como as coisas se espalham.
Materiais:
- Um pouco de farinha de trigo ou amido (representando as bactérias invisíveis).
- Uma fruta (como uma maçã).
- Uma faca de plástico (sem corte perigoso).
- Uma tábua de corte.
Leia mais: A química por trás dos alimentos ultraprocessados: do sabor ao conservante
Como fazer:
- Finja que a farinha é a sujeira invisível de uma carne crua.
- Passe a faca na farinha.
- Agora, use essa mesma faca para fingir que está cortando a maçã.
- Observe como o pó branco gruda na fruta imediatamente.
- O teste final: Tente limpar a faca apenas com um pano seco e “corte” outra parte da maçã. Você verá que ainda há resíduos passando para a fruta.
O que aprendemos: Isso mostra que apenas “passar um paninho” não remove as partículas pequenas. É necessário um agente químico, como o detergente, para quebrar a união entre a sujeira e a superfície.
Aviso de segurança: Crianças devem fazer este experimento com supervisão. Não consuma os alimentos usados no teste para garantir que ninguém coma sujeira acidentalmente.
Os três esconderijos: Tábua, Pano e Esponja
Se a contaminação tivesse um esconderijo favorito, seria um destes três itens:
1. A Tábua de Corte e a química da contaminação cruzada
As tábuas de madeira são bonitas, mas complicadas. Elas são porosas. Quando você corta carne, o suco (água e proteínas) entra nas fibras. Se a madeira não secar perfeitamente, vira um ambiente perfeito para bactérias. O ideal é ter uma tábua para carnes e outra só para vegetais e frutas.
2. O Pano de Prato
Ele é o maior veículo de transporte da cozinha. Você limpa a mão suja de ovo, depois enxuga um prato e, por fim, seca a bancada. Você acaba criando uma “mistura de resíduos” e espalhando por tudo.
++ Como a química viabiliza as células solares orgânicas
3. A Esponja
A esponja retém água e restos de comida. Sem a limpeza correta, ela apenas redistribui a sujeira em vez de removê-la.
De outra forma, para ficar mais informado sobre esse assunto, entre nesse site.
Como usar a ciência para prevenir?
A boa notícia é que a química que permite a contaminação também nos dá as ferramentas para evitá-la. O segredo está na limpeza correta.
- Detergente é fundamental: As moléculas do detergente funcionam como “ímãs” de dois lados: um lado agarra a água e o outro agarra a gordura. Elas envolvem a sujeira e as bactérias, permitindo que a água leve tudo embora. Lavar só com água não resolve, pois a gordura repele a água.
- O poder do Hipoclorito: A água sanitária é um oxidante potente. Ela desativa os micro-organismos e neutraliza moléculas de cheiro forte. Deixar vegetais de molho (1 colher de sopa para 1 litro de água) é uma medida de segurança essencial.
- Separação física: Tente não misturar os utensílios. Usar cores diferentes para facas ou tábuas ajuda a lembrar o que é para carne e o que é para salada.
Por que isso acontece?
Quando cortamos cebola e depois uma fruta na mesma tábua, ocorre a adsorção. As moléculas de cheiro da cebola grudam na superfície da faca.
Como a fruta é úmida e porosa, ela acaba puxando essas moléculas para dentro dela. Não é coisa da sua cabeça; é a transferência real de substâncias de um objeto para o outro.
Dicas práticas para o dia a dia
Para manter tudo em ordem sem estresse, adote alguns hábitos:
- Siga a ordem certa: Corte primeiro as frutas e vegetais que serão comidos crus. Só depois mexa com as carnes. Assim, o risco de levar algo da carne para a salada é quase zero.
- Lave as mãos sempre: A nossa pele tem muitas ranhuras que seguram resíduos. Trocou de ingrediente? Lave as mãos com sabão.
- Cuidado no churrasco: É comum usar o mesmo garfo para pegar a carne crua e, depois, para servir a carne pronta. Isso é contaminação na certa! Tenha utensílios separados para o “antes” e o “depois” do fogo.
- Organize a geladeira: Nunca coloque carne crua nas prateleiras de cima. O suco pode pingar nos alimentos de baixo. Carne deve ficar sempre na parte inferior ou em potes bem fechados.
Perguntas Frequentes (FAQ)
1. Posso usar vinagre para desinfetar a tábua?
O vinagre ajuda a tirar cheiros e soltar gordura, mas não é um desinfetante forte o suficiente para matar bactérias perigosas como a Salmonela. Para segurança total, use detergente e água sanitária.
2. Lavar o frango na pia ajuda?
Não! Ao lavar o frango, a água espalha gotículas microscópicas cheias de bactérias por toda a sua pia, balcão e esponja. O que mata as bactérias do frango é o calor do cozimento, não a água da torneira.
3. Devo trocar a esponja sempre?
O ideal é trocar ou desinfetar a cada semana. Uma dica: mergulhar a esponja limpa em água fervendo por alguns minutos ajuda a diminuir muito a carga de micro-organismos acumulados.
4. Tábuas de vidro são melhores?
Elas são fáceis de lavar porque não têm poros, mas estragam o corte das facas. Se usar plástico ou madeira, apenas troque-as quando estiverem com muitos riscos e sulcos profundos, onde a sujeira se esconde mais fácil.
Entender como essas trocas invisíveis acontecem transforma a nossa rotina. Cozinhar é fazer ciência todos os dias, e saber evitar a contaminação garante que o único resultado do seu experimento seja uma refeição deliciosa e segura!
